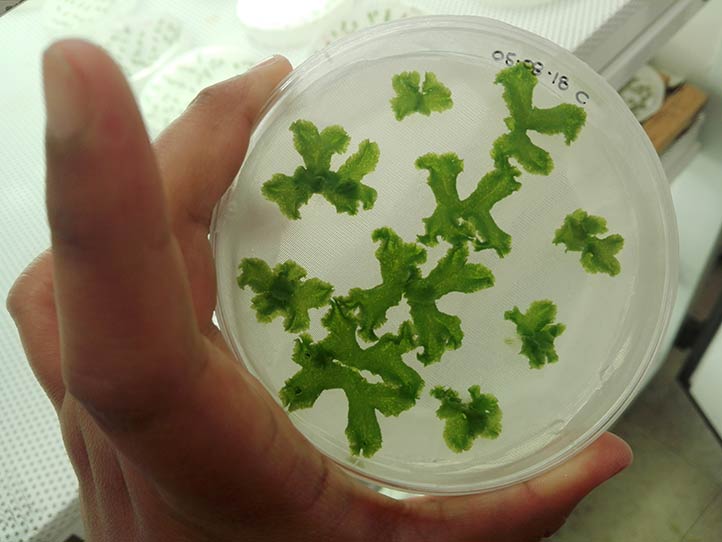

- “Me interesa saber cómo es la maquinaria de estas plantas que con el paso del tiempo han evolucionado y sobrevivido a pesar de todas las adversidades climáticas y del estrés salino”: Dulce Olivia Flores Martínez
- En 2018 realizó una estancia en la Universidad de California, Riverside, Estados Unidos
Claudia Peralta Vázquez
14/10/2020, Xalapa, Ver.- Dulce Olivia Flores Martínez, quien está a punto de concluir el Doctorado en Ciencias en Ecología y Biotecnología, del Instituto de Biotecnología y Ecología Aplicada (Inbioteca) de la Universidad Veracruzana (UV), realizó un estudio basado en la caracterización molecular de la respuesta al estrés salino en Marchantia polymorpha.
Ésta es una planta ancestral que existe desde hace 450 millones de años, y fue la primera capaz de evolucionar en un ambiente acuático y terrestre, dijo la egresada de la Licenciatura en Biología de la UV y de la Maestría en Ciencias en Ecología y Biotecnología, también de Inbioteca.
Se caracteriza por ser una planta hepática que se encuentra en ambientes húmedos, y por reproducirse de manera sexual y asexual. “Como son plantas muy primitivas no tienen hojas, tallos ni raíz, son muy similares a los musgos”, explicó.
Dulce Olivia Flores dio a conocer que la Marchantia polymorpha generalmente se ve afectada por el estrés salino, el cual inhibe el crecimiento de las plantas y afecta la agricultura en todo el mundo.
Las altas concentraciones de cloruro de sodio en los suelos afectan a las plantas y causan estrés osmótico, estrés oxidativo, inhibición del crecimiento y muerte celular cuando la exposición es prolongada.
Por tanto, la capacidad de las plantas para responder a los estímulos ambientales depende de los cambios en la expresión genética.
En este sentido, el propósito de la investigación dirigida por Ana Elena Dorantes Acosta, encargada del Laboratorio de Epigenética y Biología del Desarrollo, es conocer cómo dicha planta se ha adaptado durante todo este tiempo para sobrevivir.
“Me interesa saber cómo es la maquinaria de estas plantas que con el paso del tiempo han evolucionado y sobrevivido a pesar de todas las adversidades climáticas y del estrés salino, no es como cualquier otra, contiene el kit mínimo básico para sobrevivir a estas condiciones.”
Con este estudio pretende extrapolar la información a nuevas plantas de cultivo agrícola como el maíz, trigo, arroz, haba, etcétera. De esta forma, en un futuro y ante los embates del cambio climático, dichas plantas tendrán una mayor capacidad para tolerar esos ambientes extremos, como es el caso de la salinidad.

Dentro del doctorado en Inbioteca realiza la caracterización molecular de la respuesta al estrés salino de dicha planta
Destacó que durante el segundo semestre de este posgrado y como resultado de un proyecto de colaboración, tuvo la oportunidad de hacer una estancia de movilidad de seis meses en el Departamento de Botánica y Ciencias Vegetales de la Universidad California, Riverside, Estados Unidos, en 2018.
Ésta fue financiada por el Instituto de la Universidad de California para México y Estados Unidos (UC-MEXUS) y una beca mixta del Consejo Nacional de Ciencia y Tecnología (Conacyt).
Ahí, bajo la dirección de Julia Bailey Serres, realizó un análisis más profundo a nivel molecular de la Marchantia Polymorpha. Sobre esta experiencia, aseguró que si tuviera una nueva oportunidad la aprovecharía, toda vez que gracias a ello conoció otra cultura, hizo muchos amigos de varias partes del mundo, pero, sobre todo, logró generar conocimientos que abonaron a su proyecto de investigación.
Actualmente continúa en la elaboración y escritura de los primeros resultados para su pronta publicación. Al parecer, por la gran cantidad de información con la que cuenta, obtendrá dos artículos.
Casi a punto de finalizar el doctorado, Dulce Flores expresó sentirse afortunada por la confianza que le han brindado sus profesores de Inbioteca; más adelante aspira a realizar una estancia posdoctoral.
La joven hizo sus prácticas profesionales en Inbioteca, donde desarrolló sus primeros experimentos de modelos de cultivo in vitro. Siempre quiso estudiar la carrera de Biología, pues creció en una comunidad donde estuvo en contacto con la naturaleza. En un principio pensaba trabajar con animales, pero al paso del tiempo descubrió su interés y gusto por las plantas.
Su trabajo de tesis de licenciatura se centró en la biología molecular y genética, en el análisis de unos genes llamados argonautas.
En agosto de 2014, la investigadora ingresó a la Maestría en Ciencias en Ecología y Biotecnología, de Inbioteca, donde estudió el estrés salino de la misma planta e hizo una caracterización a nivel morfológico y de biología molecular.
La investigadora busca extrapolar la información a nuevas plantas de cultivo agrícola como el maíz, trigo, arroz y haba
Categorías: Ciencia, Principales






